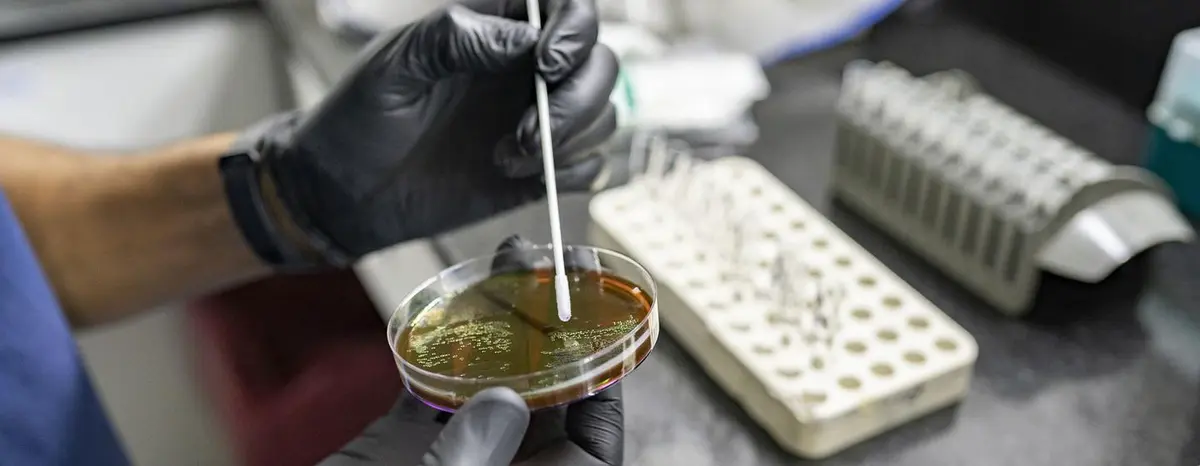

Halfway there: 5 ways the UN is turbocharging the race to the SDGs | UN News
At the halfway point towards realizing the ambitious 2030 Agenda for Sustainable Development, Member States, innovators, and influencers will gather at UN Headquarters on Monday when the UN Economic and Social Council (ECOSOC) will be showcasing post-pandemic gains made in the push towards the Sustainable Development Goals (SDGs), unveiling its latest progress report.
Average global temperatures have already risen around 1.1°C above pre-industrial levels and are likely to reach or surpass the critical 1.5°C tipping point by 2035.
Leading the way to help nations to get back on track is the Council’s High-Level Political Forum (HLPF) which began on Monday.
The Forum brings together UN Member States, alongside civil society, industry leaders and innovators, and meets through to 20 July, honing in on five of the 17 SDGs, with their work feeding into the crucial SDG Summit in September.
“Progress on the 17 Sustainable Development Goals (SDGs) is severely derailed,” ECOSOC president Lachezara Stoeva told reporters on Friday. “Marking the mid-point, we hope we can mobilize attention.”
Under the theme of accelerating a post-COVID-19 recovery, 39 countries will present success stories alongside roadblocks towards achieving the Goals, and more than 100 ministers along with civil society, academia, and innovators from around the world will offer lessons learned and an array of innovative solutions to help get to the finish line.
2. Ramping up access to clean water, sanitation, and power

At least two billion people still live without safely managed drinking water services, posing a great challenge towards realizing SDG 6.
Likewise, while the number of people without electricity shrank from 1.2 billion to 733 million between 2010 and 2020, Tracking SDG 7: The Energy Progress Report warned that current efforts are not enough to achieve the Goal on time.
Part of the problem is funding. To meet these Goals, engaging the private sector and other new partners will be key to unlocking fresh investments.
Times are already changing. Green energy is now seen as a growth sector that can create jobs and boost prosperity. In 2022, for the first time, investment in green energy exceeded that in fossil fuels, according to the UN.
The HLPF will be hearing from nations like the Central African Republic (CAR), who are making inroads, with help from developing partners. By installing new solar fields and rehabilitating the Boali hydroelectric power station, the Government of CAR increased access to electricity in cities from 14.3 per cent to 32 per cent between 2018 and 2022.
3. Reaping benefits, from robots to resilience

While the pandemic affected almost one in three jobs in the manufacturing industry, innovation investments remained resilient as corporate and government research and development budgets grew, according to the UN. The biggest boom was in venture capital, which has been very active in Africa, Latin America, and the Caribbean.
From harnessing the benefits of robots to the power of influencers like Jane Goodall, Ciara, and Yo-Yo Ma in its Circle of Supporters around the world, the UN and partners are assisting a range of initiatives to spotlight work being done to help nations drive green growth across sectors to realize SDG 9, on industry, innovation, and infrastructure.
Throughout the forum, science, technology, and innovation partnerships will be under the spotlight, alongside more than 200 side events to showcase a range of creative solutions to advancing the Goals.
A sampling of what’s on offer includes the launch of a UN-Energy policy brief, A Global Roadmap for the Just and Inclusive Clean Cooking Transition, and the Mayors Go Digital event, which promotes the Global Alliance of Mayors for Digital Cooperation to leverage these technologies for sustainable and inclusive urban development.
4.Green cities for all

Cities will be the “critical battlegrounds” on the road to realizing the 2030 Agenda, UN Secretary-General António Guterres said in June. Producing 70 per cent of global greenhouse gas emissions and housing half of humanity, cities are on the frontline for action as nations work towards greening urban landscapes.
Within 30 years, UN estimates indicate that over two thirds of people will prefer to live in large towns and cities, attracted by the advantages they offer. Vital drivers of economic growth, cities contribute over 80 per cent of global GDP.
But, in 2020, more than one billion people lived in slums or informal settlements, predominantly in Asia and sub-Saharan Africa. As urban populations grow, slums expand even faster.
SDG 11 aims at addressing these issues by making cities and human settlements inclusive, safe, resilient, and sustainable by 2030. That means finding solutions, which the forum will discuss.
This includes replacing slums and outdated housing with adequate accommodations, establishing affordable and reliable transportation systems, and ensuring access to essential services alongside creating urban environments with ample green public spaces accessible to all.
5. Innovative partnerships
The SDGs can only be achieved through strong partnerships, ECOSOC’s president said on Friday. That’s why the HLPF will be hearing from representatives of civil society, the private sector, and academia.
Part of the challenge is funding, she said, adding that “we need to include the private sector and look to new ways to finance the Goals.”
New partners are also needed, she said, noting that the media can play a significant role in amplifying ongoing efforts. Reflecting the interlinked nature of all the Goals, SDG 17 also calls for cooperation on and access to science, technology, and innovation, in part, to ensure that all nations can benefit from new developments.
Through the forum, countries and key stakeholders will share experiences and benefits from partnerships in collectively tackling some of the most pressing challenges to sustainable development, in a bid to advance progress towards achieving the SDGs and leaving no one behind.

